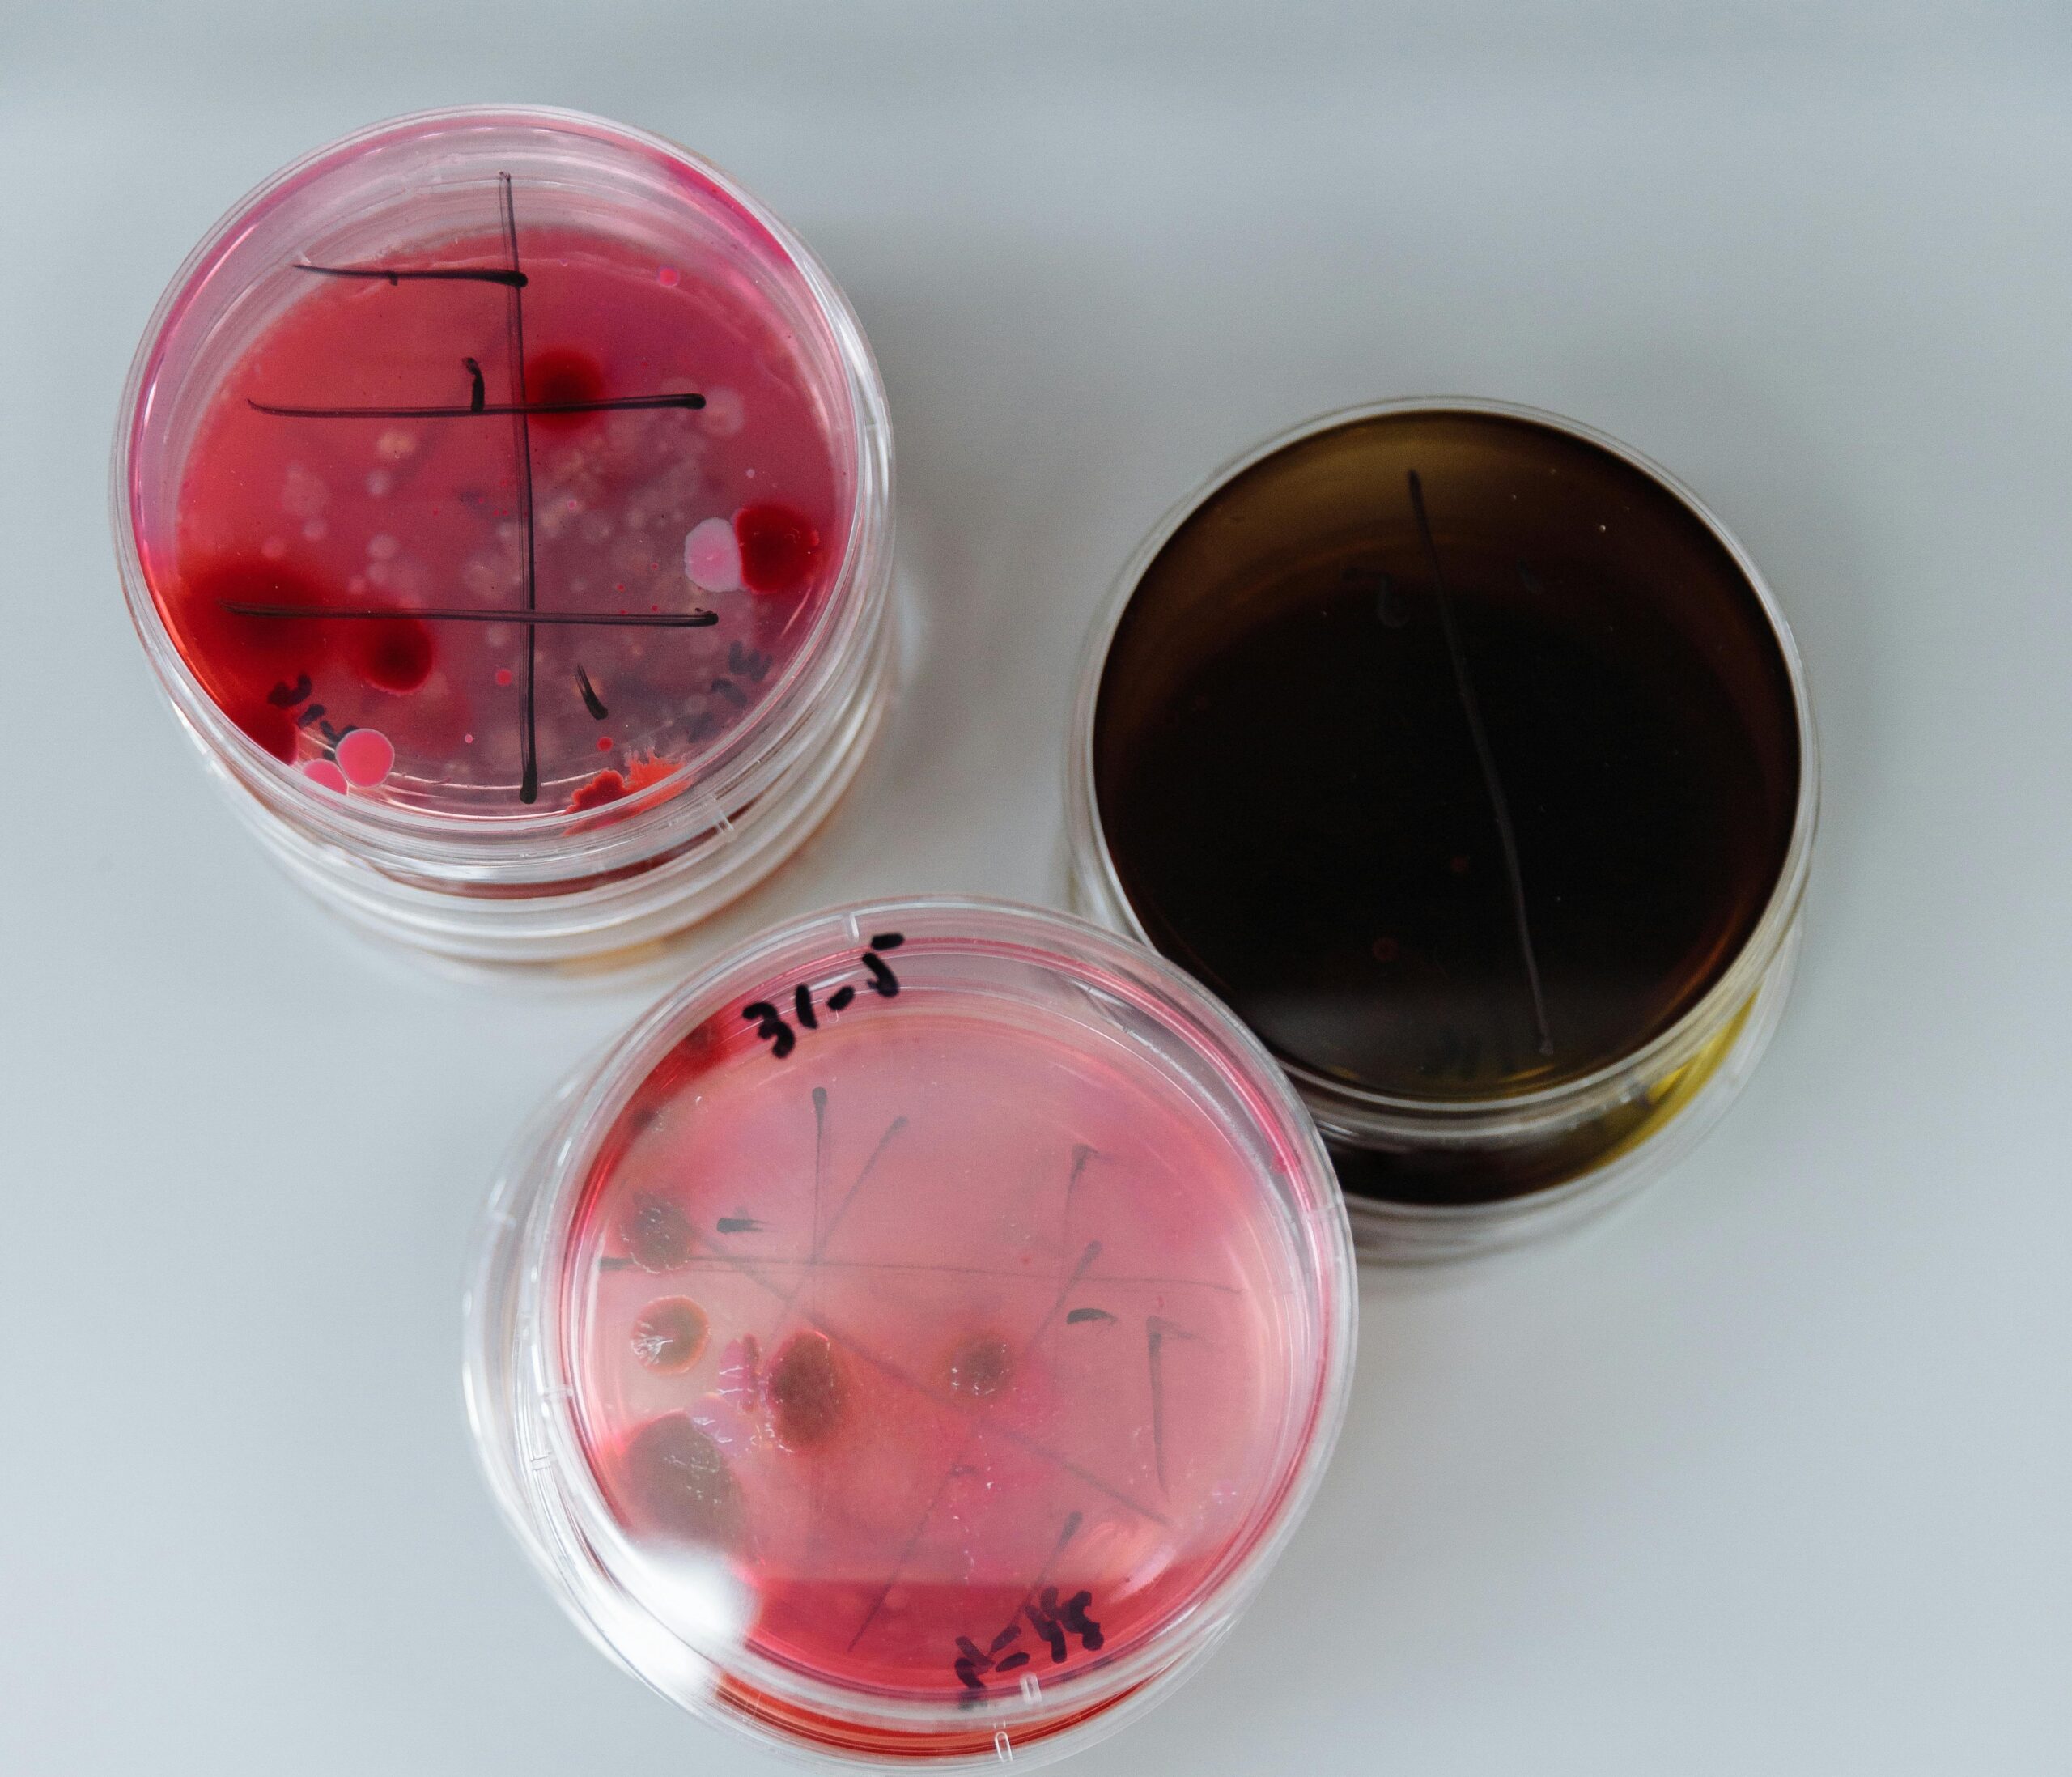
pexels thirdman 8940346 scaled

Raziskovalci univerze Northwestern University, kot je aprila objavil portal Science Daily, so razvili inovativno gorivno celico, ki za proizvodnjo električne energije izkorišča mikroorganizme, naravno prisotne v zemlji.
Naprava, velika približno kot manjša knjiga, pretvarja energijo, ki nastaja pri razgradnji organske snovi v tleh, v električni tok – dovolj za napajanje majhnih senzorjev. Ta pristop ponuja obetavno alternativo klasičnim baterijam, ki vsebujejo strupene in vnetljive materiale ter prispevajo k naraščajočemu problemu elektronskih odpadkov. Poleg tega odpravlja odvisnost od sončnih panelov, ki v naravnih okoljih pogosto niso zanesljivi.
Raziskovalna ekipa je pokazala, da lahko sistem uspešno poganja podzemne senzorje za merjenje vlage v tleh in celo zaznavanje dotika ali gibanja. Takšni senzorji bi lahko na primer spremljali premikanje živali na kmetijskih površinah.
Naprava vključuje tudi majhno anteno, ki podatke brezžično prenaša z odbojem obstoječih radijskih signalov, kar močno zmanjša porabo energije. Sistem deluje v različnih pogojih – tako v suhi zemlji kot tudi v poplavljenem okolju – in je v testih deloval približno 20 % dlje kot primerljive tehnologije.
Tehnologija temelji na t. i. mikrobnih gorivnih celicah (MFC), ki delujejo podobno kot baterije, vendar namesto kemičnih reakcij izkoriščajo bakterije. Te med razgradnjo organske snovi sproščajo elektrone, ki ustvarjajo električni tok. Ker so takšni mikroorganizmi prisotni skoraj povsod v zemlji, ima sistem potencial za dolgotrajno delovanje. Dokler je v tleh na voljo organski material, lahko gorivna celica teoretično proizvaja energijo neomejeno dolgo.
Rešitev za izzive sodobnega kmetijstva
Sodobno, t. i. precizno kmetijstvo temelji na velikem številu senzorjev, ki spremljajo vlago, hranila in onesnaževala v tleh. Vendar njihovo napajanje predstavlja velik izziv. Menjava baterij na velikih površinah je nepraktična, sončni paneli pa so občutljivi na umazanijo in odvisni od sončne svetlobe.
Nova rešitev energijo črpa neposredno iz okolja – iz zemlje same – in tako odpravlja potrebo po rednem vzdrževanju.
Preboj v zasnovi
Čeprav ideja mikrobnih gorivnih celic obstaja že več kot stoletje, je bila njihova uporaba doslej omejena zaradi nestabilnega delovanja, zlasti v suhih razmerah. Raziskovalci so to težavo rešili z novo zasnovo naprave. Namesto vzporedne postavitve elektrod so uporabili pravokotno razporeditev: anoda je nameščena vodoravno v vlažni zemlji, katoda pa navpično sega do površine, kjer ima dostop do zraka. Ta konfiguracija zagotavlja hkratno prisotnost vlage in kisika – ključnih pogojev za delovanje sistema. Naprava je zaščitena s posebnim pokrovom, ki preprečuje vdor umazanije, hkrati pa omogoča pretok zraka. Deluje tudi v primeru poplav, saj se lahko po umiku vode postopoma posuši.
Obetavni rezultati in prihodnost
V terenskih testih je naprava delovala zanesljivo v različnih pogojih – od zmerno suhe zemlje do popolnoma poplavljenih območij – in proizvedla kar 68-krat več energije, kot je potrebna za delovanje senzorjev.
Raziskovalci poudarjajo, da tehnologija ni namenjena napajanju velikih sistemov, vendar ima velik potencial za uporabo v nizkoenergijskih napravah, kot so senzorji v kmetijstvu, okoljski monitoring in hitro rastoče omrežje interneta stvari (IoT).
V prihodnje želijo razviti še popolnoma biorazgradljive različice naprav, ki bi dodatno zmanjšale vpliv na okolje in omogočile lokalno proizvodnjo iz dostopnih materialov.
Nova tehnologija tako odpira vrata trajnostnim, samostojnim sistemom, ki bi lahko bistveno poenostavili spremljanje okolja in kmetijskih procesov – brez baterij, brez kablov in z minimalnim vplivom na naravo.